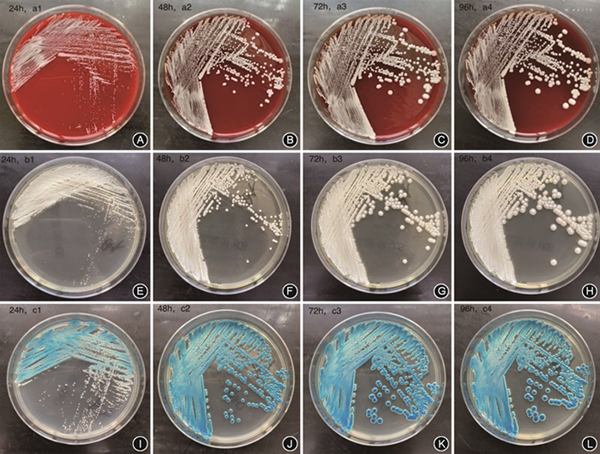

分析临床1例脑梗死患者体温达38.4 ℃时外周静脉血及导管血检出的长孢洛德酵母菌的生物学特性,观察科玛嘉念珠菌显色平板的菌落形态和醋酸钠培养基上子囊孢子的产生情况,利用Vitek 2 compact、基质辅助激光解吸/电离飞行时间质谱(MALDI-TOF MS)、测序分析分别进行鉴定,并进行药敏试验研究,以提高实验室对该菌的鉴定水平。药敏试验结果显示此例分离株对多种抗真菌药物的MIC值较低。临床给予拔除中心静脉置管,并使用抗真菌药物治疗至最后一次血培养阳性后2周,用药期间多次复查血培养均为阴性,患者无发热,各项感染指标基本降至正常,可供临床参考。
版权归中华医学会所有。
未经授权,不得转载、摘编本刊文章,不得使用本刊的版式设计。
除非特别声明,本刊刊出的所有文章不代表中华医学会和本刊编委会的观点。
患者,男,63岁。25 d前无明显诱因突发头晕,伴恶心、呕吐及步态不稳,至西安交通大学第一附属医院就诊,查数字减影血管造影提示:“左侧椎动脉V4段狭窄,右侧小脑上动脉血栓形成”,头颅磁共振弥散加权成像提示“延髓梗死”,住院期间出现四肢活动障碍,伴痰多,监测血氧饱和度下降,以“呼吸衰竭”先后行气管插管、气管切开及呼吸机辅助呼吸等治疗,以及“头孢哌酮舒巴坦钠”抗感染治疗。9 d后脱离呼吸机,可自主呼吸,但一直痰多、发热,体温高。为进一步治疗至西安交通大学第二附属医院就诊。入院时,体温:37.6 ℃,脉搏:92次/min,呼吸:29次/min,血压:156/105 mmHg(1 mmHg=0.133 kPa),气管切开状态,神志清,被动体位,查体欠合作。双侧呼吸动度减低,叩诊清音,双肺呼吸音低,可闻及痰鸣音。左上肢肌力0级,左下肢肌力Ⅰ级,右上肢肌力Ⅲ+级,右下肢肌力Ⅱ+,左侧上下肢肌张力减低,右侧肌张力正常,双侧Babinski症阳性,CT显示双下肺肺炎,既往有广谱抗生素使用史,横结肠黏膜慢性炎症及癌变、糖尿病及高血压史等。入院后第7天体温达38.4 ℃时,白细胞11.24×109/L、中性粒细胞10.42×109/L、白细胞介素6为87.04 ng/L、降钙素原0.902 μg/L,并采集外周静脉血及导管血培养,外周静脉血报阳时间30 h 43 min,导管血报阳时间为28 h 26 min。本研究经医院伦理委员会批准(2021253),并取得患者知情同意。
将分离株接种于哥伦比亚血琼脂、沙保弱琼脂培养基(Sabouraud dextrose agar,SDA)、科玛嘉念珠菌显色平板上35 ℃大气环境培养,分别观察24、48、72和96 h菌落形态(图1),菌落湿润、白色、光滑,科玛嘉念珠菌显色平板上培养24 h,菌落密集区呈蓝绿色,单个菌落呈白色,24 h后逐渐呈蓝绿色;取哥伦比亚血平板上培养24 h菌落涂片进行革兰染色后镜下可观察到卵圆形孢子;将分离株接种于醋酸钠培养基室温培养,每天对菌落进行抗酸染色,观察子囊孢子产生情况[1]。第2天开始能观察到长椭圆形的淡粉色的子囊孢子,菌体为蓝色(图2)。

取SDA上培养24 h的菌落,于0.45%盐水中配备成2.0麦氏浊度的菌悬液,采用Vitek YST卡在Vitek 2 compact全自动微生物鉴定仪进行鉴定,结果为近平滑念珠菌,可信度94%。同时取哥伦比亚血平板24 h培养的少量菌落直接点在靶板上,加1 μl 70%甲酸溶液进行蛋白裂解,干燥后加1 μl基质液充分混匀,干燥后上VITEK MS全自动快速微生物质谱仪进行鉴定,结果为长孢洛德酵母菌,可信度为99.9%。
收集SDA上培养24 h的纯菌落,送往擎科生物公司进行一代测序。使用TSINGKE植物DNA提取试剂盒(通用型),按照试剂盒使用说明书提取菌株DNA。将提取的DNA样品适量稀释后作为PCR模版,以擎科1×TSE101金牌mix进行扩增,扩增体系各组分如下:1×TSE101金牌mix 45 μl,ITS1(10P)2 μl,ITS4(10P)2 μl,DNA模板1 μl;PCR反应条件:预变性98 ℃ 2 min;变性98 ℃ 10 s;退火56 ℃ 10 s;72 ℃ 10 s/kb,35个循环;延伸72 ℃ 5 min。
将扩增好的PCR产物在琼脂糖凝胶中电泳(2 μl样本+6 μl溴酚蓝),300 V电压下12 min,获取PCR产物进行测序,将测序结果与NCBI数据库进行比对,与数据库中长孢洛德酵母菌ZA035(登录号:GQ280291.1)同源性为100%。
药物敏感性试验:取SDA培养24 h菌落并制备0.5麦氏浓度的菌悬液,取20 μl菌悬液加入真菌药敏液中混匀,试剂板每孔加入混匀后的真菌药敏液100 μl,密封后于35 ℃培养箱中温育24 h后进行结果判读。分离株对检测药物的MIC分别为:两性霉素B(0.12 mg/L)、米卡芬净(0.06 mg/L)、卡泊芬净(0.06 mg/L)、氟胞嘧啶(0.12 mg/L)、泊沙康唑(0.12 mg/L)、伏立康唑(0.015 mg/L)、伊曲康唑(0.12 mg/L)、氟康唑(0.25 mg/L)、艾沙康唑(0.015 mg/L)。
血培养分离株鉴定过程中,因Vitek YST真菌鉴定卡结果与科玛嘉念珠菌显色平板结果不符,于是进行MALDI-TOF MS和测序,结果均为长孢洛德酵母菌。明确病原菌后给予拔除中心静脉置管,使用卡波芬净50 mg、氟康唑400 mg1次/d静滴,同时使用哌拉西林钠他唑巴坦钠4.5 g 1次/8 h静滴,至最后一次血培养阳性后两周。最后一次阳性血培养为首次阳性血培养后第6天,治疗期间多次复查血培养均为阴性,无发热,各项感染指标基本降至正常[2]。
讨论 长孢洛德酵母菌在哥伦比亚血平板及SDA上培养24 h菌落呈白色、湿润、光滑质地,在科玛嘉念珠菌显色平板上呈蓝绿色。易与常见的白念珠菌、热带念珠菌等相混淆,而后二者在科玛嘉显色平板上分别显绿色和蓝灰色。通过芽管试验可以鉴别白念珠菌与长孢洛德酵母菌,白念珠菌呈阳性,而长孢洛德酵母菌为阴性[3]。
本例分离菌株经MALDI-TOF MS、基因测序比对结果均为长孢洛德酵母菌,但经Vitek 2 compact误鉴定为近平滑念珠菌,以往多次报道Vitek 2 compact可将长孢洛德酵母菌误鉴定为近平滑念珠菌[4, 5, 6]。长孢洛德酵母菌与白念珠菌、热带念珠菌以及近平滑念珠菌有较高的序列相似度,但彼此之间又有明显差异[7]。在玉米粉琼脂上,长孢洛德酵母菌和近平滑念珠菌均可以形成大量的假菌丝[4],但二者在科玛嘉显色平板上显色不同,近平滑念珠菌呈白色或淡粉色菌落。
长孢洛德酵母菌与白念珠菌、都柏林念珠菌、热带念珠菌、近平滑念珠菌等在系统发育中同属一个分支[8],但长孢洛德酵母菌被认为是该分枝中唯一产子囊孢子的菌株[6]。将长孢洛德酵母菌接种于醋酸钠培养基上室温培养,于第2天经抗酸染色,便可观察到含有长椭圆形的淡粉色子囊孢子的蓝色菌体。因醋酸钠培养基缺乏氮源,且存在不可发酵性碳源(醋酸盐),将分离株接种于醋酸钠培养基上室温培养,可促进其在减数分裂时期形成子囊孢子。子囊孢子的形成情况,多在其他方法模棱两可时用于鉴定[1]。
在国内很多基层实验室无法常规开展MALDI-TOF MS或者测序,而Vitek YST真菌鉴定卡易将长孢洛德酵母菌误诊,应结合科玛嘉显色平板上菌落形态以及醋酸钠培养基上子囊孢子的产生情况加以鉴定。
本例分离株为中心静脉置管的脑干梗死患者,鉴定结果和药敏谱均相同,其余肺泡灌洗液、尿培养等均未培养出长孢洛德酵母菌,《血管内导管相关感染的预防与治疗指南》[2]的确诊依据之一:从导管和外周静脉同时抽血做定性血培养,中心静脉导管血培养阳性出现时间比外周血培养阳性至少早2 h,故考虑为导管相关性血流感染。与Ahmad等[6]报道的相同,本分离株仅在需氧瓶中生长,但Al-Obaid等[9]的病例报道显示该菌在需氧瓶和厌氧瓶均有生长。据报道,长孢洛德酵母菌可以引起导管相关性血流感染、血流感染及心内膜炎等[3, 4, 5, 6,9, 10, 11],也有长孢洛德酵母菌与近平滑念珠菌混合感染的报道[12],至今感染机制未明,可能与免疫抑制、癌症等因素有关。本例分离株的MIC值均较低,然而因为分离株较少,目前国际上尚无统一的药敏试验标准和药敏折点判断标准。本例患者在拔除中心静脉置管,同时使用卡波芬净联合氟康唑至最后一次阳性血培养2周后停药。以往的报道既有使用棘白菌素类药物治疗成功的病例[3,11],也有拔除中心静脉置管并使用氟康唑治疗后血培养转阴的病例[6]。
目前,可能由于实验室对长孢洛德酵母菌的认识不足,鉴别能力不高,导致实际感染长孢洛德酵母菌的检出率较低,或者将长孢洛德酵母菌误鉴定为近平滑酵母菌或者其他念珠菌[13],从而可能延误治疗时机并增加患者的经济负担和死亡率。所以,应综合利用多种检测方法,提高实验室对该菌的鉴别能力。
所有作者声明无利益冲突





















